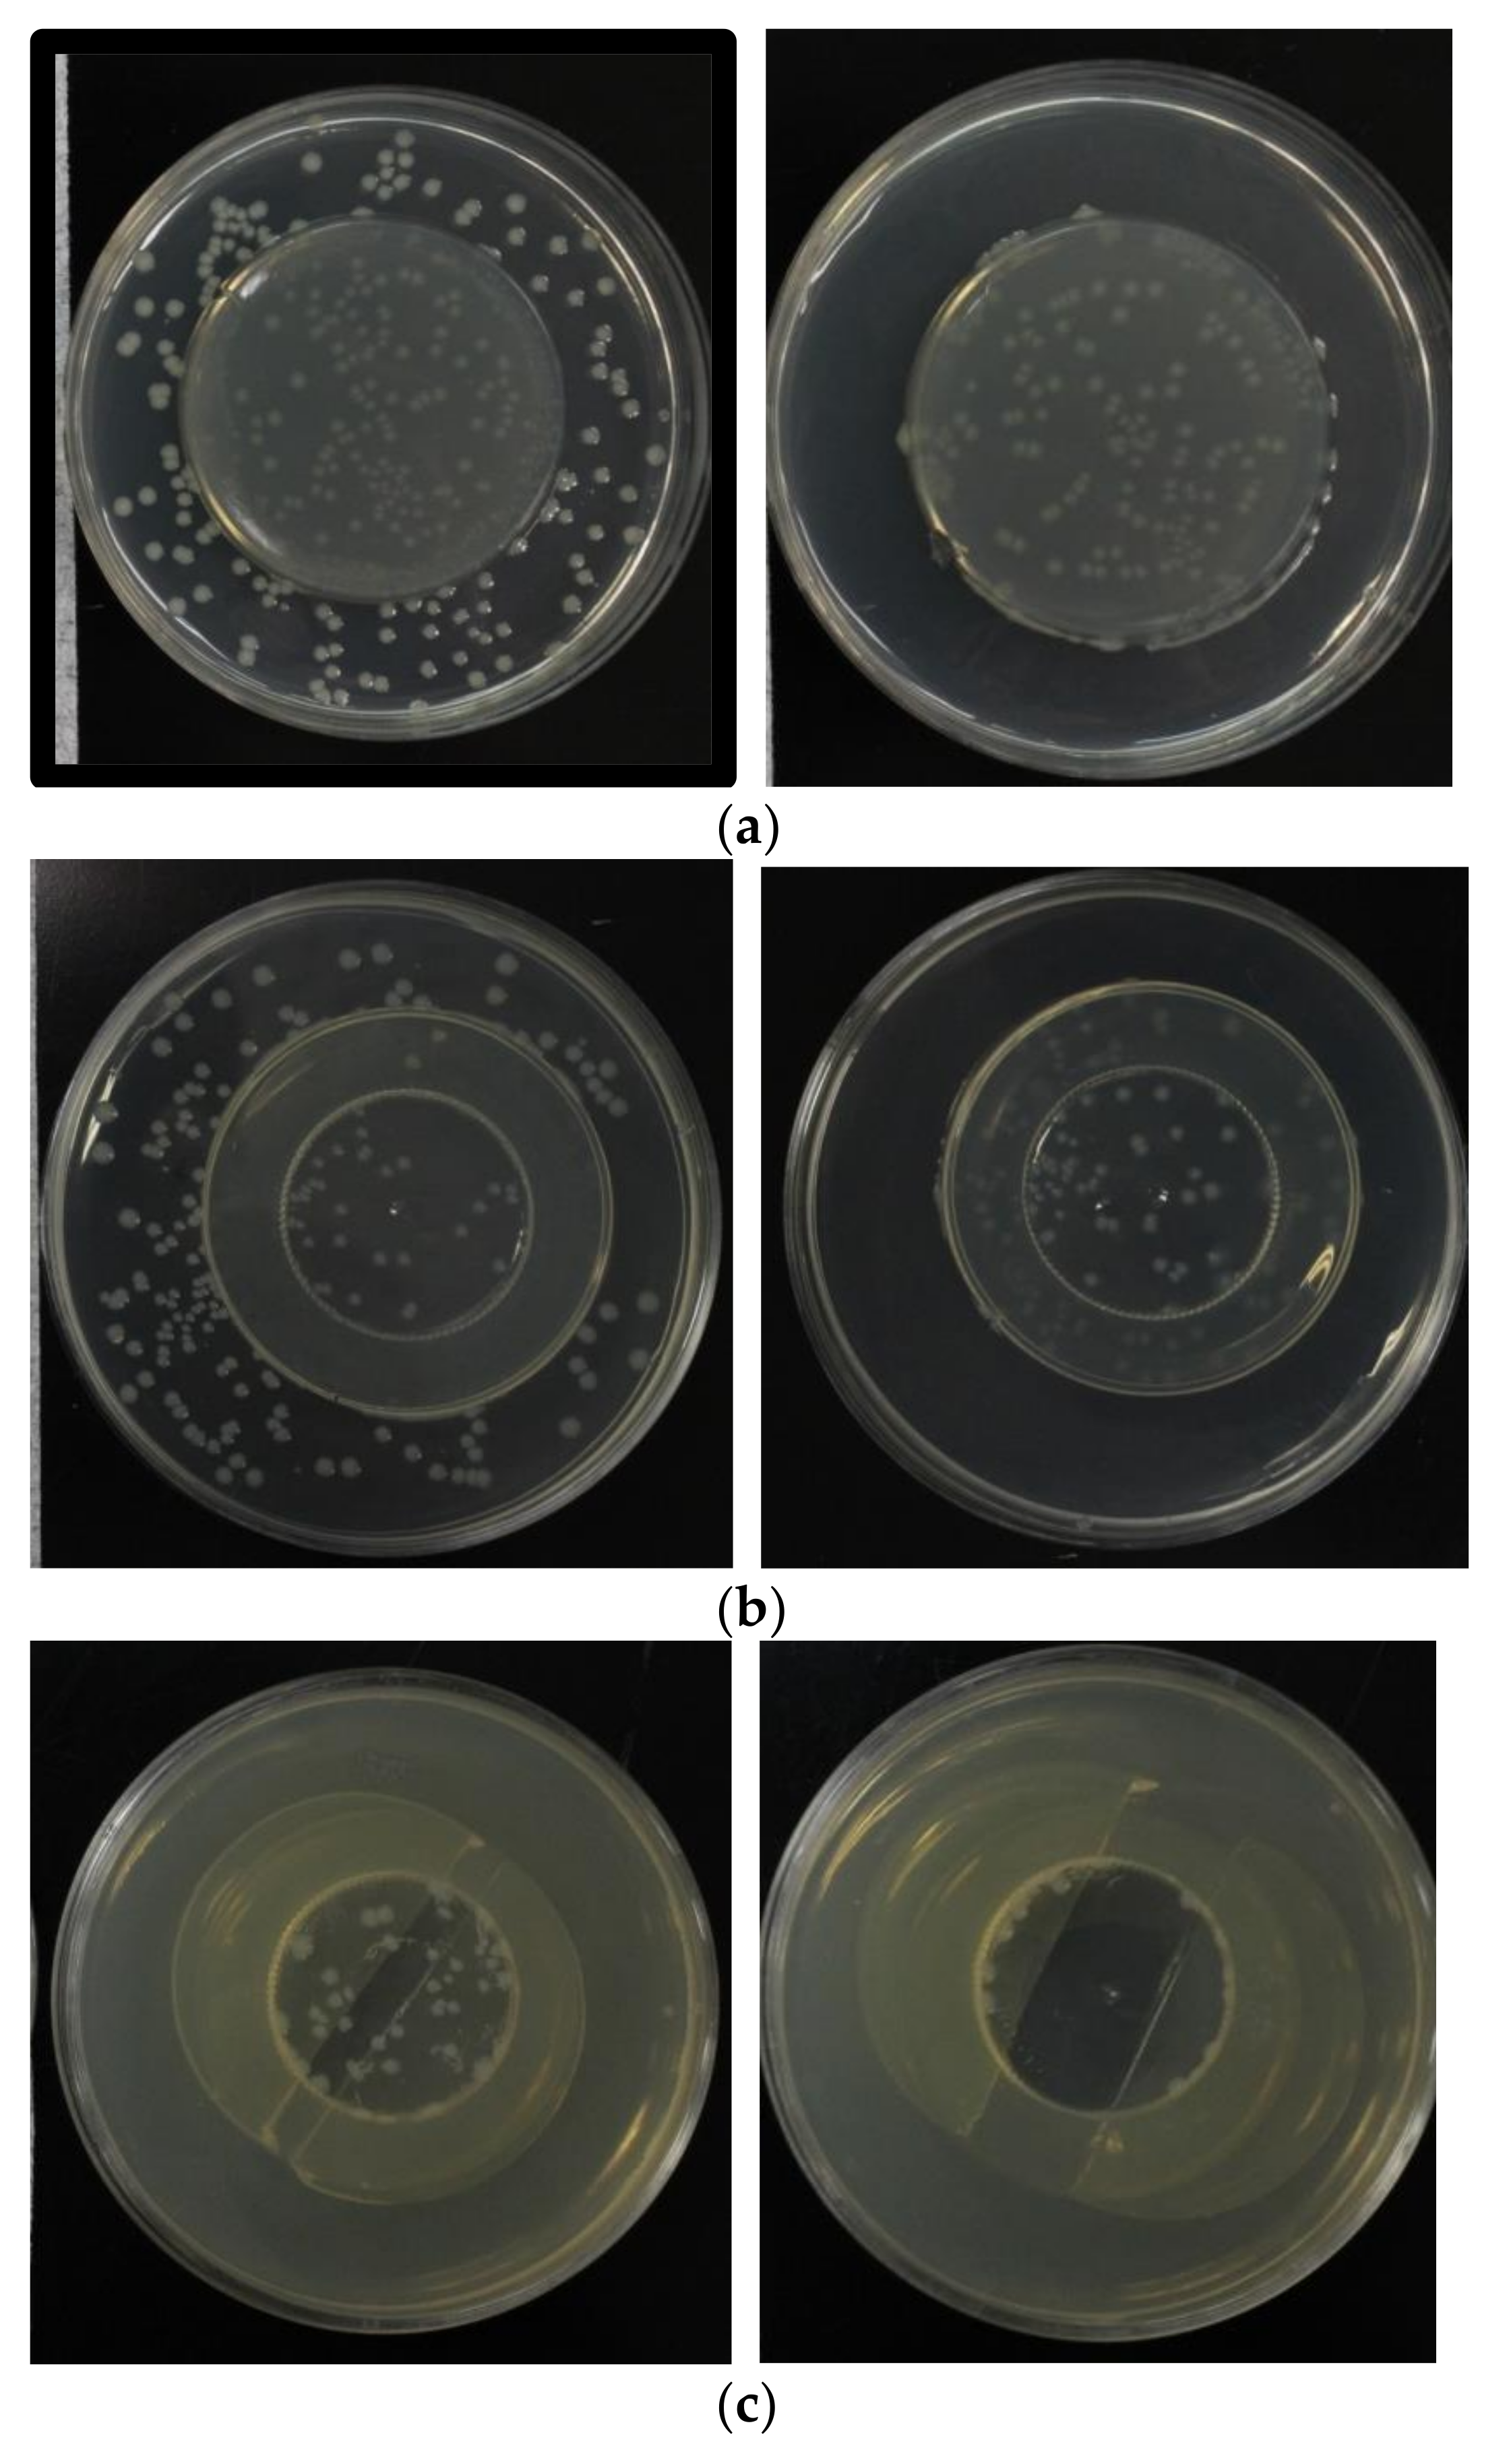
Agronomy 12 00822 g009 550

Investigation of Sterilization Effect for Overlapping Pieces in Non-Thermal Sterilization Method of Packaged Fresh Foods Using Pulsed Barrier Discharge
Abstract
:1. Introduction
2. Experimental Setup
3. Experimental Result
3.1. Sterilization Effect by Pulsed Plasma to Microorganisms Living on the Food Surface
3.2. Investigation of Sterilization Effect by the Influx of the Active Species
3.3. Investigation of Ozone Inflow to the Hollow through the Slit
3.4. Improvement of Sterilization Effect for the Hollow Made by Stacking the Pieces
4. Conclusions
- (1)
- The surface contacting with the plasma of the food packaged in the container can be easily sterilized.
- (2)
- The sterilization ratio depends on the magnitude of the discharge energy of the plasma.
- (3)
- When there is no air in the overlapped pieces, there is no bactericidal effect by the plasma.
- (4)
- A hollow sealed completely by the pieces of food cannot be sterilized because it has a low electric field such that the plasma does not occur.
- (5)
- Active species, such as ozone, generated by the plasma are diffusible, and, if a minute gap exists between foods, the active species can invade inside the gap and sterilize microorganisms. However, since those lifetimes are not so long, many pulses are necessary to generate a large number of the active species.
- (6)
- The pulsed plasma can be generated in the hollow made by sandwiching the dielectric film between the pieces of food, and microorganisms can be sterilized.
- (7)
- When the depth of the hollow made by sandwiching the dielectric film between the pieces of food becomes deep, the electric field in the hollow becomes low and the bactericidal effect becomes weak.
5. Patents
Author Contributions
Funding
Data Availability Statement
Acknowledgments
Conflicts of Interest
References
- Klockow, P.A.; Keener, K.M. Safety and quality assessment of packaged spinach treated with a novel ozone-generation system. LWT-Food Sci. Technol. 2009, 42, 1047–1053. [Google Scholar] [CrossRef]
- Pankaj, S.K.; Bueno-Ferrer, C.; Misra, N.N.; Milosavljević, V.; O’Donnell, C.P.; Bourke, P.; Keener, K.M.; Cullen, P.J. Applications of cold plasma technology in food packaging. Trends Food Sci. Technol. 2014, 35, 5–17. [Google Scholar] [CrossRef]
- Akitsu, T.; Ohkawa, H.; Tsuji, M.; Kimura, H.; Kogama, M. Plasma sterilization using glow discharge at atmospheric pressure. Surf. Coat. Technol. 2005, 193, 29–34. [Google Scholar] [CrossRef]
- Wan, J.; Coventry, J.; Swiergon, P.; Sanguansri, P.; Versteeg, C. Advances in innovative processing technologies for microbial inactivation and enhancement of food safety—pulsed electric field and low-temperature plasma. Trends Food Sci. Technol. 2009, 20, 414–424. [Google Scholar] [CrossRef]
- Muranyi, P.; Wunderlich, J.; Heise, M. Sterilization efficiency of a cascaded dielectric barrier discharge. J. Appl. Microbiol. 2007, 103, 1535–1544. [Google Scholar] [CrossRef] [PubMed]
- Miao, H.; Yun, G. The sterilization of Escherichia coli by dielectric-barrier discharge plasma at atmospheric pressure. Appl. Surf. Sci. 2011, 257, 7065–7070. [Google Scholar] [CrossRef]
- Choi, J.H.; Han, I.; Baik, H.K.; Lee, M.H.; Han, D.W.; Park, J.C.; Lee, I.S.; Song, K.M.; Lim, Y.S. Analysis of sterilization effect by pulsed dielectric barrier discharge. J. Electrost. 2006, 64, 17–22. [Google Scholar] [CrossRef]
- Kostov, K.G.; Rocha, V.; Koga-Ito, C.Y.; Matos, B.M.; Algatti, M.A.; Honda, R.Y.; Kayama, M.E.; Mota, R.P. Microorganisms sterilization by a dielectric barrier discharge (DBD) in air. Surf. Coat. Technol. 2010, 204, 2954–2959. [Google Scholar] [CrossRef]
- Schwabedissen, A.; Lacinski, P.; Chen, X.; Engemann, J. A new method to disinfect goods inside a closed package using dielectric barrier discharges. Contrib. Plasma Phys. 2007, 47, 551–558. [Google Scholar] [CrossRef]
- Ziuzina, D.; Patil, S.; Cullen, P.J.; Keener, K.M.; Bourke, P. Atmospheric Cold Plasma Inactivation of Escherichia Coli in Liquid Media Inside a Sealed Package. J. Appl. Microbiol. 2013, 114, 778–787. [Google Scholar] [CrossRef] [PubMed]
- Klämpfl, T.G.; Isbary, G.; Shimizu, T.; Li, Y.F.; Zimmermann, J.L.; Stolz, W.; Schlegel, J.; Morfill, G.E.; Schmidt, H.U. Cold Atmospheric Air Plasma Sterilization against Spores and Other Microorganisms of Clinical Interest. Appl. Environ. Microbiol. 2012, 75, 5077–5082. [Google Scholar] [CrossRef] [PubMed] [Green Version]
- Lee, K.; Paek, K.; Ju, W.; Lee, Y. Sterilization of microorganisms, yeast, and microorganisms endospores by atmospheric-pressure cold plasma using helium and oxygen. Microbiology 2006, 44, 269–275. [Google Scholar]
- Misra, N.N.; Tiwari, K.B.; Raghavarao, K.S.M.S.; Cullen, J.P. Nonthermal Plasma Inactivation of Food-Borne Pathogens. Food Eng. Rev. 2011, 3, 159–170. [Google Scholar] [CrossRef] [Green Version]
- Misra, N.N. In-package atmospheric pressure cold plasma treatment of cherry tomatoes. J. Biosci. Bioeng. 2014, 118, 177–182. [Google Scholar] [CrossRef] [PubMed] [Green Version]
- Ma, Y.; Zhang, J.G.; Shi, M.X.; Xu, M.G.; Yang, Y. Chemical Mechanisms of Microorganisms Inactivation Using Dielectric Barrier Discharge Plasma in Atmospheric Air. IEEE Trans. Plasma Sci. 2008, 36, 1615–1620. [Google Scholar] [CrossRef]
- Sun, Y.; Qiu, Y.; Nie, A.; Wang, X. Experimental Research on Inactivation of Microorganisms by Using Dielectric Barrier Discharge. IEEE Trans. Plasma Sci. 2007, 35, 1496–1500. [Google Scholar] [CrossRef]
- Akiyama, H.; Katsuki, S.; Kanazawa, S.; Shimomura, S.; Takaki, K.; Tsukamoto, S.; Minamitani, Y.; Yamashita, T. High Voltage Pulsed Power Technology; Ohmsha: Tokyo, Japan, 2003; pp. 147–148. (In Japanese) [Google Scholar]
- Electrostatics Toolkit. Field Precision LLC. Available online: https://www.fieldp.com/estat.html (accessed on 27 November 2021).
- Rasband, W.S. National Institutes of Health, Bethesda, Maryland, USA. 1997–2022. Available online: https://imagej.nih.gov/ij/ (accessed on 1 November 2021).
- Schneider, C.A.; Rasband, W.S.; Eliceiri, K.W. NIH Image to ImageJ: 25 years of image analysis. Nat. Methods 2012, 9, 671–675. [Google Scholar] [CrossRef] [PubMed]

| Parameter (Unit) | Value |
|---|---|
| Applied Voltage (kV) | 70, 85 |
| Repetition rate (pps) | 10 |
| Number of Applying pulses (shots) | 5~100 |
| Material | Relative Permittivity | Conductivity [mS/cm] | Magnitude of Complex Relative Permittivity |
|---|---|---|---|
| Air | 1 | 5 × 10−15 | 1 |
| Petri dish (polystyrene) | 2.5 | <10−16 | 2.5 |
| Agar medium | 81 | 10 | 3596 |
Publisher’s Note: MDPI stays neutral with regard to jurisdictional claims in published maps and institutional affiliations. |
© 2022 by the authors. Licensee MDPI, Basel, Switzerland. This article is an open access article distributed under the terms and conditions of the Creative Commons Attribution (CC BY) license (https://creativecommons.org/licenses/by/4.0/).
Share and Cite
Saito, K.; Onuma, T.; Ota, D.; Sato, Y.; Minamitani, Y. Investigation of Sterilization Effect for Overlapping Pieces in Non-Thermal Sterilization Method of Packaged Fresh Foods Using Pulsed Barrier Discharge. Agronomy 2022, 12, 822. https://doi.org/10.3390/agronomy12040822
Saito K, Onuma T, Ota D, Sato Y, Minamitani Y. Investigation of Sterilization Effect for Overlapping Pieces in Non-Thermal Sterilization Method of Packaged Fresh Foods Using Pulsed Barrier Discharge. Agronomy. 2022; 12(4):822. https://doi.org/10.3390/agronomy12040822
Chicago/Turabian StyleSaito, Koki, Takafumi Onuma, Daichi Ota, Yoshihiro Sato, and Yasushi Minamitani. 2022. "Investigation of Sterilization Effect for Overlapping Pieces in Non-Thermal Sterilization Method of Packaged Fresh Foods Using Pulsed Barrier Discharge" Agronomy 12, no. 4: 822. https://doi.org/10.3390/agronomy12040822
APA StyleSaito, K., Onuma, T., Ota, D., Sato, Y., & Minamitani, Y. (2022). Investigation of Sterilization Effect for Overlapping Pieces in Non-Thermal Sterilization Method of Packaged Fresh Foods Using Pulsed Barrier Discharge. Agronomy, 12(4), 822. https://doi.org/10.3390/agronomy12040822

